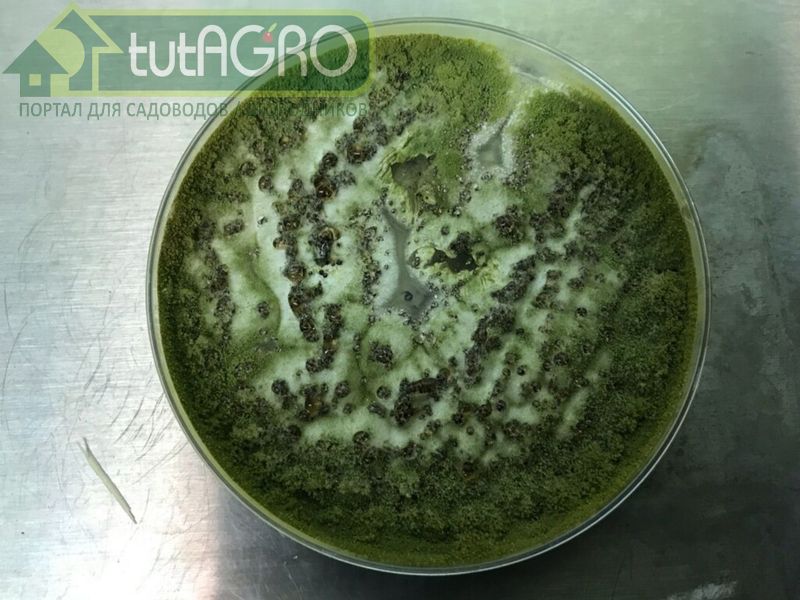
Метаризиум - современный способ борьбы с вредителями - AGROzen

Большой проблемой в саду и огороде является повреждение растений вредителями, особенно почвенными. Медведка, личинки различных хрущей, в первую очередь майского, проволочник и многие другие наносят огромный вред корневой системе растений.
Больше других от повреждений почвенных вредителей страдают молодые посадки плодовых деревьев, земляника и смородина. Немалый ущерб саду наносят и наземные вредители: саранча и кузнецы, листоеды, пяденицы, листовертки, совки и прочие разнообразные гусеницы. Немало досаждают в саду и огороде муравьи.

Для борьбы с вредителями широко применяются различные токсичные препараты на основе химически синтезированных веществ, которые оказывают вредное воздействие и на окружающую среду, и на человека. А между тем, многие вредители приобрели устойчивость к синтетическим инсектицидам.

Современным же способом борьбы с вредителями является использование безопасных для растений и большинства животных, пчел и дождевых червей, а также человека особых паразитических грибов. Среди них широко используются грибы рода Метаризиум - естественные природные гиперпаразиты насекомых-вредителей.

Два очень активных изолята Метаризиума, поселяющихся на поверхности и внутренностях разнообразных вредителей, включая саранчу, личинок и имаго хрущей, колорадского жука и некоторых видов муравьев, входят в состав субстрата «Защитник сада и огорода». Буквально через несколько дней после заселения гриба вредители не просто перестают питаться и обездвиживаются, но при попадании на почву или в почве даже успевают начать разлагаться, возвращая питательные вещества растениям. Если же гриб не встретился с вредителем, он переходит на питание растительными остатками и, как и триходерма, способствует увеличению плодородия почвы.
Читайте также: Знакомьтесь - триходерма

Препарат «Защитник сада и огорода» эффективен против иксодовых клещей. Применяя этот препарат регулярно, вы не только оздоровите сад, но и убережете свою семью и домашних питомцев от нападений клещей.
Изоляты грибов рода Метаризиум в составе субстрата «Защитник сада и огорода», как и грибы рода Триходерма:
- способствуют конкурентной борьбе с болезнями растений,
- оказывают непосредственное антибиотическое влияние на ряд фитопатогенов, в особенности на возбудителей фузариоза, пурпуровой пятнистости (дидимеллы) малины, аскохитоза гороха, стеблевого рака томата, ризоктониоза (черной парши) картофеля, серой гнили земляники и других растений.
Иван Русских рекомендует!
Только в журнале "Урожайные сотки" Вы можете получать дельные рекомендации, уникальные советы, рецепты от специалиста-биолога, известного блогера Ивана Русских.
Оформите подписку прямо сейчас! Жители Беларуси могут оформить подписку тут. Жители России сюда!
Автор: Иван Русских